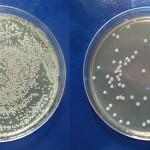
Ossido di grafene: possibile futuro utilizzo contro i batteri del cavo orale

Bambini e paura del dentista: studiarla, valutarla e superarla
Troppo spesso viene sottovalutato lo stato di stress e paura che i piccoli pazienti devono affrontare quando vanno dal dentista. L'uso di una buona...
Bambini: come rendere la visita odontoiatrica meno traumatica
Le visite odontoiatriche devono riuscire ad essere meno traumatiche possibile, soprattutto per i bambini. Spegnere lampade troppo forti, proiettare sul soffitto immagini, accompagnate con...
ANDI: no alla diminuzione posti in Odontoiatria
Dopo la firma, avvenuta nei giorni scorsi, del Ministro dell’Università Ricerca ed Istruzione Stefania Giannini, i posti disponibili nei corsi di Odontoiatria quest'anno saranno...
Riforma degli Ordini, il giudizio di Andrea Senna, vicepresidente Omceo di Milano
La notizia è di pochi giorni fa. Il provvedimento non piace alle rappresentanze professionali di medici e odontoiatri, farmacisti e veterinari (complessivamente oltre mezzo milione di iscritti) che hanno espresso un giudizio negativo sul testo approvato dalla Camera. Abbiamo incontrato Andrea Senna, neoeletto vicepresidente dell’Ordine dei medici chirurghi e degli odontoiatri di Milano.
AIO: l’odontoiatra è un ottimo medico estetico
«Nella legge 409 che ha istituito la professione di odontoiatra, si parla esplicitamente di diagnosi e terapia non solo dei denti e della bocca,...
Un maestro dell’ergonomia
Basta scambiare qualche parola con Daniele Beretta per accorgersi che l’ergonomia non è solo un concetto. È uno stile di vita, un modo nuovo,...
Si è spento Ennio Giannì
Si è spento a Bergamo il Professor Ennio Giannì. Giannì è stato primario, poi professore e preside universitario, professore emerito della Università Statale di...
Diagnosi e sintomi celiachia: come valutare chi è predisposto a questa patologia
La celiachia pur non essendo una patologia che interessa solamente il cavo orale, può avere degli effetti proprio anche sul distretto di competenza dell'odontoiatra....
Ricominciamo dall’odontoiatria pediatrica
È quanto sembra voler suggerire Raffaella Docimo, professore ordinario di Odontoiatria Pediatrica presso l’Università degli Studi di Roma Tor Vergata. Madre di tre figli, ha rinunciato alla libera professione per...
I Dentisti italiani a confronto con i nuovi scenari offerti dal web
Pubblichiamo la seconda parte dei risultati di Odontoiatri e Web, il sondaggio online condotto da GRS Ricerca e Strategia per “Il Dentista Moderno. La restante...
Eccellenza clinica e sostenibilità delle cure
È all’interno di questo perimetro che Enrico Manca, 40 anni, cagliaritano, odontoiatra libero professionista, ma anche relatore apprezzato in Italia e all’estero, pratica l’odontoiatria...
Ossido di grafene: possibile futuro utilizzo contro i batteri del cavo orale
Le patologie orali causate dall'eccessiva presenza di batteri sono il più comune problema di salute al mondo. E' stato scoperto che l'ossido di grafene...
Corso di Formazione in Assistente di Studio Odontoiatrico
La Facoltà di Medicina e Odontoiatria della Sapienza Università di Roma propone anche per l’anno accademico 2014/2015 il Corso di Formazione in Assistente di...
Autorizzazioni studi odontoiatrici Lazio: il video del presidente AIO
Non saranno più necessarie le autorizzazione per gli studi odontoiatrici, siano essi singoli, associati o “poli-medici”, così come per i medici di famiglia convenzionati;...
Il viaggio di un chirurgo nel mare dell’implantologia
È quello di Andrea Edoardo Bianchi, 51 anni, milanese, Presidente Eletto della Società Italiana di Chirurgia Orale e Implantologia. Dal 2004 è Titolare dell’Insegnamento...
ANDI contro le Catene Odontoiatriche: Prada difende i diritti dei pazienti
Hanno fatto molto discutere negli ultimi giorni gli emendamenti proposti da ANDI per estendere uguali diritti anche ai cittadini che decidono di rivolgersi a...